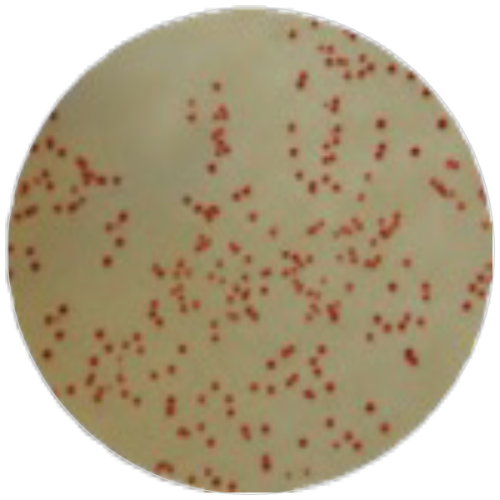
Агар с ТТХ для подсчета общего микробного числа MF002

Агар с ТТХ для подсчета общего микробного числа
Описание
Подсчета ОМЧ, в составе индикатор TTC – колонии окрашены в красный цвет
Рекомендуется для культивирования микроорганизмов в образцах воды, сточных вод, молока, продуктов питания, сырья, напитков и других образцах.
Контроль качества
Описание: сухая питательная подложка бледного цвета диаметром 50 мм, с фильтром.
Реакция посева
Характерная реакция посева после инкубации при температуре 35−37 °C
в течение 18−24 часов.
Доступные артикулы:
MF002-50PT
Рекомендуется для культивирования микроорганизмов в образцах воды, сточных вод, молока, продуктов питания, сырья, напитков и других образцах.
Контроль качества
Описание: сухая питательная подложка бледного цвета диаметром 50 мм, с фильтром.
Реакция посева
Характерная реакция посева после инкубации при температуре 35−37 °C
в течение 18−24 часов.
Доступные артикулы:
MF002-50PT
Характеристики
Области применения
Вода, молоко, продукты питания и другие образцы, сточные воды, напитки
Документация
HiMedia Laboratories Pvt. Ltd. - абсолютный лидер по ассортименту поставляемых питательных сред.